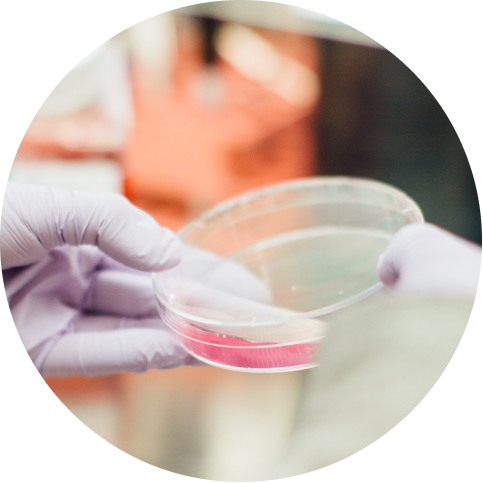

Breadcrumb
Home - McKesson Canada
Améliorer les soins de santé pour tous ™
Nous touchons pratiquement tous les aspects de la santé
En tant que leader diversifié dans le domaine de la santé, nous offrons des solutions qui aident les patients à accéder à des thérapies qui changent leur vie. Qu’il s’agisse, entre autres, de livrer le tiers de tous les médicaments au Canada, d’accueillir les patients dans nos pharmacies ou d’établir des partenariats avec les parties prenantes du secteur de la santé, nous poursuivons notre objectif d'améliorer les soins de santé pour tous.

Améliorer les soins de santé pour tous ™
Nous touchons pratiquement tous les aspects de la santé
En tant que leader diversifié dans le domaine de la santé, nous offrons des solutions qui aident les patients à accéder à des thérapies qui changent leur vie. Qu’il s’agisse, entre autres, de livrer le tiers de tous les médicaments au Canada, d’accueillir les patients dans nos pharmacies ou d’établir des partenariats avec les parties prenantes du secteur de la santé, nous poursuivons notre objectif d'améliorer les soins de santé pour tous.
Distribution
Soins de santé spécialisés
Solutions pour les pharmacies de détail
Solutions technologiques d'automatisation
mckca_homePressReleasenew


En vedette :
Médicaments pour les maladies rares au Canada : Considérations relatives pour un accès équitables
Favoriser un accès équitable aux traitements spécialisés et pour les maladies rares — en mettant à profit une expertise approfondie en soutien aux patients, en distribution et en services pharmaceutiques afin d’aider les Canadiens à obtenir les soins dont ils ont besoin, au moment où ils en ont besoin.


En vedette :
Médicaments pour les maladies rares au Canada : Considérations relatives pour un accès équitables
Favoriser un accès équitable aux traitements spécialisés et pour les maladies rares — en mettant à profit une expertise approfondie en soutien aux patients, en distribution et en services pharmaceutiques afin d’aider les Canadiens à obtenir les soins dont ils ont besoin, au moment où ils en ont besoin.
Histoires & perspectives
Dimitris Polygenis nommé nouveau président de McKesson Canada
Mississauga, ON (1er octobre 2025)– McKesson Canada a le plaisir d’annoncer la nomination de Dimitris Polygenis, cadre chevronné, au poste de président de McKesson Canada.
Avec plus de 20 ans d’expérience chez McKesson Canada, Dimitris Polygenis a contribué de façon significative à la transformation et à la croissance de l’organisation, assumant des rôles de direction dans les domaines du commerce de détail, de la distribution pharmaceutique et, plus récemment, à la direction de la division des Soins de santé spécialisés. Il a joué un rôle de premier plan dans le succès de Phase 4 Health, une compagnie intégrée par la suite à McKesson, en lançant un nouveau modèle d’affaires offrant des thérapies spécialisées innovantes et axées sur le client, contribuant ainsi à redéfinir les soins de santé au Canada. Sous son leadership, l’équipe des Soins de santé spécialisés a continué à développer des programmes révolutionnaires et à investir de façon stratégique dans la technologie et l’analyse des données afin d'accélérer l’accès aux soins, améliorer l’adhérence et optimiser les résultats.
C’est un grand honneur d’assumer cette responsabilité, et je suis impatient de continuer à travailler avec cette équipe talentueuse et passionnée ainsi qu’avec les intervenants de l’ensemble du système de santé canadien », a déclaré M.Polygenis. «McKesson Canada possède une longue tradition de leadership et d’innovation pour répondre aux besoins de nos clients, prestataire de soins, partenaires et patients, et je m’engage à poursuivre en ce sens avec une contribution positive et durable pour tous».
M.Polygenis est titulaire d’un doctorat en pharmacie de l’Université de Toronto. Il a siégé au sein de plusieurs conseils d’administration dans le secteur des soins de santé, notamment pour l’Université de Toronto et pour les programmes de pharmacie de l’Université de la Colombie-Britannique, ainsi que comme président de l’Association canadienne de la gestion de l'approvisionnement pharmaceutique. Il siège actuellement aux conseils d’administration de l’Association canadienne des pharmacies de quartier et de l’Association des pharmaciens du Canada, où il préside le National Pharmacy Business Council.
M. Polygenis succède à Joan Eliasek, qui occupe maintenant le poste de présidente de la distribution pharmaceutique nord-américaine, dans le cadre de la nouvelle structure organisationnelle de McKesson Corporation.
Dimitris est un chef d’entreprise chevronné qui possède une vaste expérience dans tous nos secteurs d’affaires et une connaissance approfondie de notre industrie» a déclaré Mme Eliasek. «L’engagement de Dimitris envers l’excellence et sa détermination à livrer des résultats pour les clients et les patients le placent en excellente position pour diriger McKesson Canada dans ce nouveau chapitre.»
À propos de McKesson Canada
McKesson Canada est un chef de file diversifié dans le domaine des services de soins de santé qui se consacre à améliorer les résultats en matière de santé pour les patients de partout au pays. Nos équipes collaborent avec des compagnies pharmaceutiques, des fournisseurs de soins, des pharmacies, des fabricants, des gouvernements et d’autres partenaires afin d’offrir des produits, des services et des perspectives permettant de rendre les soins de qualité plus accessibles et abordables. Apprenez-en davantage sur l’impact de McKesson Canada sur pratiquement tous les aspects des soins de santé au: www.McKesson.ca.
Personne-ressource pour les média:
Melissa Turgeon
Chef principale, Affaires publiques, Québec, McKesson Canada
media@mckesson.ca
McKesson Canada élargit l'accès des patients à la thérapie de pointe par radioligands en Ontario
Mississauga, Ontario (le 24 mars 2025) – McKesson Canada est ravie d'annoncer qu'elle offre désormais aux patients la thérapie par radioligands (RLT) dans sa toute nouvelle clinique de perfusion INVIVA située à Toronto. Il s’agit de la première fois que ce traitement innovant est proposé aux patients en dehors d'un milieu hospitalier en Ontario.
« En offrant la thérapie par radioligands chez INVIVA, nous élargissons l'accès à ce traitement transformateur pour les patients de la province entière, tout en renforçant notre engagement à faire progresser les soins aux patients », déclare Dimitris Polygenis, président, Soins de santé spécialisés, McKesson Canada.
La thérapie par radioligands représente une percée en médecine nucléaire, offrant une approche ciblée qui peut améliorer considérablement les résultats de santé des patients atteints de diverses formes de cancer. En administrant une dose de radiation directement aux cellules cancéreuses, la RLT accroît la précision et l’efficacité du traitement, tout en minimisant l'impact sur les tissus sains.
L'organisation a beaucoup investi dans l'infrastructure et la certification nécessaires pour fournir des services de médecine nucléaire de manière sûre et efficace. Le personnel a suivi une formation approfondie et la clinique détient une licence de la Commission canadienne de sûreté nucléaire (CCSN), qui exige le respect de normes d'assurance qualité rigoureuses.
« À l’heure actuelle, seuls quelques médicaments de RLT sont disponibles au Canada, principalement pour traiter certaines formes de cancer, telles que les tumeurs de la prostate et les tumeurs neuroendocrines. Cependant, nous savons qu'il s'agit d'un domaine médical qui évolue rapidement », déclare Lee Steele, vice-présidente, INVIVA, et cheffe des soins infirmiers, McKesson Canada. « Nous avons estimé qu'il était important d'investir dans une clinique ayant la capacité de fournir ces traitements de pointe afin d'améliorer les résultats de santé des patients en Ontario. »
Pour en savoir davantage sur la RLT offerte dans la toute nouvelle clinique d'INVIVA, visitez inviva.ca/fr/therapie-par-radioligands.
À propos d’INVIVA
Créé en 2013, INVIVA est aujourd’hui le plus grand réseau de cliniques de perfusion privées au Canada, comptant 68 cliniques INVIVA qui offrent aux patients une thérapie spécialisée dans un environnement empreint de bienveillance et de compassion. L’équipe experte d'INVIVA travaille directement avec les fabricants pour prodiguer des thérapies et des soins infirmiers de spécialité aux patients qui en ont besoin tout en en améliorant l'accès. Elle collabore avec les prestataires de soins de santé pour améliorer l'expérience du patient et pour faciliter la gestion des patients souffrant de maladies complexes. Le personnel infirmier chevronné et hautement qualifié aide à gérer divers domaines thérapeutiques aussi variés que la gastro-entérologie, la rhumatologie, la gériatrie et la pédiatrie. En 2023, INVIVA a été agréée dans le traitement du cancer, les soins à domicile, les soins ambulatoires, la gestion des médicaments, la prévention et le contrôle des infections, ainsi que le leadership, devenant ainsi le seul réseau national agréé de cliniques privées de perfusion.
À propos de McKesson Canada
McKesson Canada est un chef de file dans le domaine des services de santé diversifiés qui se consacre à améliorer des résultats en matière de santé des patients. Nos équipes collaborent avec les sociétés pharmaceutiques, les prestataires de soins, les pharmacies, les fabricants, les gouvernements et d’autres parties prenantes afin de fournir des produits, des services et des connaissances permettant de rendre les soins de qualité plus accessibles et abordables. Apprenez-en davantage sur l’impact de McKesson sur pratiquement tous les aspects des soins de santé au www.McKesson.ca.
Personne-ressource pour les médias :
Sybil Millar
Conseillère principale, Relations avec les médias et communications externes, McKesson Canada
media@mckesson.ca
La Corporation McKesson procède à la clôture de la vente des entreprises canadiennes Rexall et Well.ca
Le 31 décembre 2024 (IRVING, Texas) – La Corporation McKesson (NYSE : MCK) a annoncé aujourd'hui qu’elle avait finalisé, le 30 décembre 2024, la transaction communiquée en septembre dernier, visant la vente de ses entreprises canadiennes Rexall et Well.ca à Birch Hill Equity Partners, une société canadienne de capital-investissement. Cette transaction permet à McKesson de concentrer le déploiement de son capital et de prioriser les investissements pour développer ses plateformes de croissance stratégiques en oncologie et en biopharmacie.
Des détails supplémentaires concernant la vente sont disponibles sur le site web des Relations avec les investisseurs de la société.
À propos de la Corporation McKesson
La corporation McKesson est un chef de file diversifié en matière de services de soins de santé qui se consacre à améliorer des résultats en matière de soins de santé des patients du monde entier. Nos équipes collaborent avec les sociétés biopharmaceutiques, les fournisseurs de soins, les pharmacies, les fabricants, les gouvernements et d’autres intervenants afin de fournir des perspectives, des produits et des services permettant de rendre les soins de qualité plus accessibles et abordables. Apprenez-en davantage sur l’impact de McKesson sur pratiquement tous les aspects des soins de santé sur McKesson.com et faites la lecture de Nos histoires.
Mises en garde
Exception faite des renseignements historiques, les déclarations contenues dans ce communiqué de presse au sujet d’un déploiement de capital, des investissements et des plateformes de croissance peuvent constituer des « énoncés prospectifs » dans la mesure prévue par l’article 27A de la Loi de 1933 sur l’émission de valeurs mobilières et de l’article 21E de la Loi de 1934 sur les opérations de bourse qui comportent des risques et des incertitudes pouvant faire en sorte que les résultats réels diffèrent grandement de ceux indiqués dans ces déclarations. Il n’est pas possible d’identifier tous ces risques et incertitudes. Le lecteur ne doit pas se fier indûment aux énoncés prospectifs, qui ne sont pertinents qu’à la date de leur publication. Sauf dans la mesure requise par la loi, la société n’est aucunement tenue de mettre à jour publiquement les déclarations prospectives. Nous encourageons les investisseurs à lire les facteurs de risque importants décrits dans le plus récent formulaire 10-K de la compagnie déposé auprès de la Commission des valeurs mobilières. Ces facteurs de risque comprennent, sans toutefois s’y limiter : nous pourrions ne pas réussir à atteindre nos objectifs de croissance stratégique; notre utilisation de données tierces est soumise à des limitations qui pourraient entraver la croissance de notre activité de services de données; nous pourrions être affectés négativement par des changements dans les environnements économiques dans lesquels nous opérons ; et nous pourrions être touchés négativement par des événements hors de notre contrôle, comme des problèmes de santé publique répandus, des catastrophes naturelles, des événements politiques et d’autres événements catastrophiques.
Personne-ressource pour les relations avec les investisseurs
Rachel Rodriguez
469 260-2556
Rachel.Rodriguez@McKesson.com
Personne-ressource pour les relations avec les médias
mckca_homeEvolveHealth
En vedette :
INVIVA : Le principal réseau de cliniques privées de perfusion au Canada agréées dans le traitement du cancer
Soins d’infusion accrédités, soutenus par plus de 300 infirmières — élargissant l’accès aux traitements contre le cancer et accompagnant les patients aux côtés des médecins et de la pharmacie McKesson SPS.


En vedette :
INVIVA : Le principal réseau de cliniques privées de perfusion au Canada agréées dans le traitement du cancer
Soins d’infusion accrédités, soutenus par plus de 300 infirmières — élargissant l’accès aux traitements contre le cancer et accompagnant les patients aux côtés des médecins et de la pharmacie McKesson SPS.


